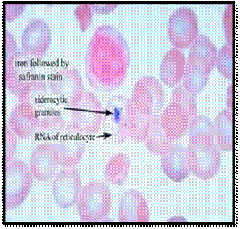

DEFINISI
v Sebagai parasit malaria memasuki aliran darah,ia menjangkiti dan memusnahkan sel darah merah.
v Malaria dikelaskan sebagai serebrum apabila ia ditunjukkan dengan gejala serebrum, seperti koma.

CIRI-CIRI @ MORFOLOGI
v Pemusnahan sel-sel ini perlu membawa kepada demam dan gejala-gejala seperti selesema, seperti sejuk-sejuk, sakit kepala, sakit otot, keletihan, loya muntah, dan cirit-birit.
v Malaria adalah dianggap tidak rumit apabila tanda-tanda wujud, tetapi tiada tanda-tanda klinikal atau makmal untuk menunjukkan keterukan atau organ penting dysfunction
v Malaria yang teruk (hanya disebabkan oleh P. falciparum)
v Jangkitan P. falciparum, jika tidak dirawat dengan segera, boleh dengan cepat kemajuan kepada malaria teruk.
v Gejala-gejala utama malaria teruk termasuk koma, sesak nafas yang teruk, gula dalam darah yang rendah, dan hemoglobin darah rendah (anemia teruk).
ETIOLOGI
1.Jenis-jenis parasit
Ø Malaria disebabkan oleh parasit protozoa daripada genus Plasmodium - organisma sel tunggal yang tidak boleh hidup di luar tuan rumah (s).
Ø Plasmodium falciparum adalah bertanggungjawab bagi majoriti kematian malaria di seluruh dunia dan spesis yang paling lazim di sub-Sahara Afrika. Spesis yang tinggal tidak biasanya sebagai mengancam nyawa sebagai P. falciparum.
Ø Plasmodium vivax, kedua spesies yang paling penting dan luas di Asia Tenggara dan Amerika Latin. P. vivax dan Plasmodium ovale telah komplikasi ditambah peringkat hati yang tidak aktif, yang boleh diaktifkan semula dalam ketiadaan gigitan nyamuk, yang membawa kepada gejala-gejala klinikal.
Ø P. ovale dan Plasmodium malariae hanya mewakili peratusan yang kecil dari jangkitan.
2 .kitaran hayat
v Parasit malaria disebarkan oleh berturut-turut menjangkiti dua jenis semesta alam: nyamuk Anopheles perempuan dan manusia.
v Dalam semua spesies Plasmodium, parasit ini berkembang untuk membentuk schizonts (peringkat multinucleate semasa sel pembiakan berjantina), dari mana beberapa ribu merozoites membangunkan
v Di Plasmodium vivax dan Plasmodium ovale sahaja, sebahagian parasit hati-peringkat (dikenali sebagai hypnozoites) kekal tidak aktif dalam hepatosit itu.
v Dalam peringkat ini, parasit boleh kekal tidak aktif untuk beberapa bulan atau beberapa tahun. Oleh itu, kedua-dua spesies daripada parasit boleh memulakan kitaran pembiakan berjantina menyebabkan gejala-gejala klinikal dalam ketiadaan gigitan nyamuk yang baru, memberi P. vivax jangkitan nama Berulang malaria.
v Apabila sel-sel pecah hati, merozoites dilepaskan ke dalam aliran darah di mana mereka dengan cepat menyerang sel-sel darah merah. Parasit darah-peringkat meniru asexually - pesat mencapai beban parasit yang tinggi dan memusnahkan setiap sel darah merah mereka menjangkiti, yang membawa kepada gejala-gejala klinikal malaria.
DIAGNOSIS
v Kawalan dan pembasmian malaria menuntut pendekatan yang pelbagai rupa. Tiada alat yang boleh mengalahkan parasit. Pada masa ini kita mempunyai pelbagai alat-alat yang baik, termasuk semburan racun serangga dan tahan lama kelambu dirawat dengan racun serangga membantu untuk mengelakkan penyebaran jangkitan melalui vektor nyamuk. Tetapi tiada strategi pencegahan adalah 100% berkesan - akan sentiasa ada kes-kes yang slip melalui bersih.
v WHO-semasa yang disyorkan rawatan barisan pertama bagi majoriti kes-kes malaria adalah berasaskan terapi gabungan artemisinin (ACT). Ubat-ubatan ini, sebagai tambahan kepada diagnostik, terdapat untuk merawat dan dalam kes-kes tertentu, mencegah malaria. Walau bagaimanapun, jurang dalam gudang senjata kami kekal
v Profilaksis jangka panjang melalui vaksinasi adalah sesuatu yang mencabar. Calon vaksin malaria yang paling maju kini dalam ujian klinikal dan diharapkan akan disediakan pada tahun-tahun akan datang.
Empat alat penting yang diperlukan untuk mengalahkan malaria
v Ia didiagnosis berdasarkan kehadiran parasit P. falciparum dan salah satu daripada gejala-gejala di atas dengan sebab lain yang tidak jelas. Kanak-kanak khususnya tidak bernasib baik kerana mereka mempunyai sedikit atau tidak ada imuniti untuk parasit. Jika tidak dirawat, malaria yang teruk boleh membawa kepada kematian.
Malaria serebral (hanya disebabkan oleh P. falciparum).
SUMBER: PELAJAR YANG MENGAMBIL SUBJEK INI.